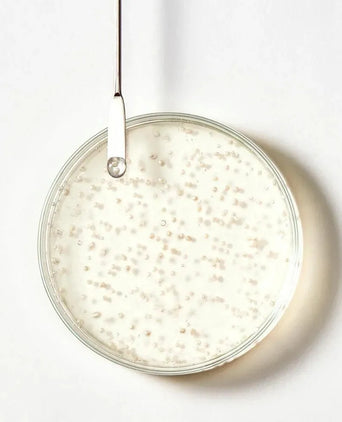

Kaikki tuotteet naisille
Erityisesti naisille suunnitellut hiusten kasvutuotteemme täyttävät ainutlaatuiset hiustenhoitotarpeet. Nämä tuotteet toimivat kohdistamalla ne päänahkaan ja hiustupiin, edistämällä tervettä kasvua ja vähentämällä harvennusta. Ne tarjoavat välttämättömiä ravintoaineita ja kosteutusta varmistaen, että naisten hiukset pysyvät vahvoina, elinvoimaisina ja täynnä elämää.
-
-0% Määräalennus Alennus SetSpectral.F7-seerumi + Revita.SOD-tabletit & Neofollics-shampooSpectral.F7-seerumi + Revita.SOD-tabletit & Neofollics-shampooStressistä johtuva hiustenlähtö, 3 pcs- Myyntihinta
- €93,46
- Normaalihinta
-
€109,95
-
-0% Määräalennus Alennus SetBeaver Brazilian Keratin Heat Protector + Shampoo + HoitoaineBeaver Brazilian Keratin Heat Protector + Shampoo + HoitoaineVaurioituneet hiukset, 3 kpl- Myyntihinta
- €32,17
- Normaalihinta
-
€37,85
-
-0% Määräalennus Alennus LoppuunmyytyBeaver Biotin & Caffeine Thickening Serum + Shampoo + HoitoaineBeaver Biotin & Caffeine Thickening Serum + Shampoo + HoitoaineHiusten oheneminen, 3 kpl- Myyntihinta
- €42,37
- Normaalihinta
-
€49,85
-
-0% Määräalennus Alennus LoppuunmyytyBeaver Biotiini & Kofeiini paksunnosseerumi (100 ml)Beaver Biotiini & Kofeiini paksunnosseerumi (100 ml)Hiusten oheneminen, 100 ml- Myyntihinta
- €19,95
- Normaalihinta
-
-
-0% Määräalennus Alennus LoppuunmyytyBeaver Argan Oil & Keratin repair shampoo (350 ml)Beaver Argan Oil & Keratin repair shampoo (350 ml)Vaurioituneet hiukset, 350 ml- Myyntihinta
- €11,95
- Normaalihinta
-
-
-0% Määräalennus Alennus -
-0% Määräalennus Alennus AlennusmyyntiKlorane shampoo bar Citrus - rasvaiset hiukset (80 gr)Klorane shampoo bar Citrus - rasvaiset hiukset (80 gr)Rasvaiset hiukset, 80 gr- Myyntihinta
- €10,63
- Normaalihinta
-
€12,50
-
-0% Määräalennus Alennus AlennusmyyntiKlorane kylmävahaliuskat karvanpoisto - kasvot ja herkät alueetKlorane kylmävahaliuskat karvanpoisto - kasvot ja herkät alueetEi-toivottu karvankasvu, 6 kpl- Myyntihinta
- €11,82
- Normaalihinta
-
€13,90
-
-0% Määräalennus Alennus UusiScandinavian Biolabs Sea Mineral Spray sea salt sprayScandinavian Biolabs Sea Mineral Spray sea salt sprayHiusten muotoilu, 100 ml- Myyntihinta
- €15,00
- Normaalihinta
-
-
-0% Määräalennus Alennus Shakebar Castor Oil & Olive Oil korjaava shampooShakebar Castor Oil & Olive Oil korjaava shampooAfrotukka/4c, 250 ml- Myyntihinta
- €7,95
- Normaalihinta
-
-
-0% Määräalennus Alennus Foligain hoitoaine naisille (236 ml)Foligain hoitoaine naisille (236 ml)Kuivat hiukset, 236 ml- Myyntihinta
- €29,95
- Normaalihinta
-
-
-0% Määräalennus Alennus SetRené Furterer Okara Silver hopea shampoo + hoitoaineRené Furterer Okara Silver hopea shampoo + hoitoaineAnti-keltainen, 2 kpl- Myyntihinta
- €36,47
- Normaalihinta
-
€42,90
-
-0% Määräalennus Alennus AlennusmyyntiRené Furterer Triphasic-shampooRené Furterer Triphasic-shampooKuivat hiukset, 200 ml- Myyntihinta
- €18,70
- Normaalihinta
-
€22,00
-
-0% Määräalennus Alennus SetKlorane silver shampoo + hoitoaineKlorane silver shampoo + hoitoaineAnti-keltainen, 2 kpl- Myyntihinta
- €28,05
- Normaalihinta
-
€33,00
-
-0% Määräalennus Alennus Veta shampoo + hoitoaine matkapakkausVeta shampoo + hoitoaine matkapakkausKuivat hiukset, 2x 100 ml- Myyntihinta
- €20,95
- Normaalihinta
-
-
-0% Määräalennus Alennus Minimalist Maleic Bond Repair Complex 05% hiusnaamioMinimalist Maleic Bond Repair Complex 05% hiusnaamioVaurioituneet hiukset, 200 g- Myyntihinta
- €19,95
- Normaalihinta
-